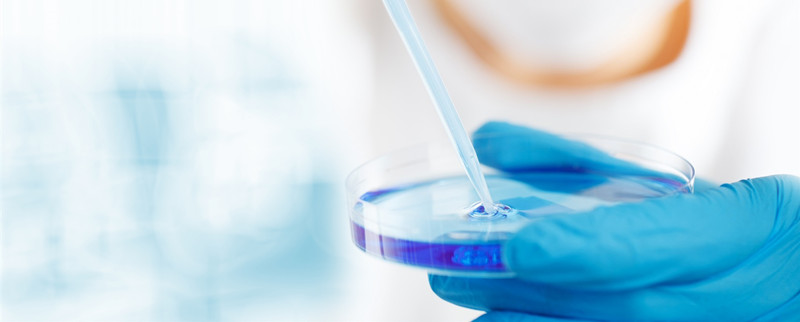
氨气溶于水吗 氨气是不是极易溶于水

氨气溶于水吗(去除氨氮的最好方法)
更新时间:2023-04-10 00:07:07作者:未知
氨气溶于水,而且极易溶于水,是一种无色的气体,但是有强烈的刺激气味,化学式是NH3。氨气在高温时会分解成氮气和氢气,有还原作用。有催化剂存在时可被氧化成一氧化氮。用于制液氮、氨水、硝酸、铵盐和胺类等。
氨气的危害
氨气的危害特别点,在使用的途中一定要做好防护措施。氨气可由氮和氢直接合成而制得,能灼伤皮肤、眼睛、呼吸器官的粘膜,人吸入过多,能引起肺肿胀,以至死亡。
如果患者只是单纯接触氨气,并且没有皮肤和眼的刺激症状,则不需要清除污染。假如接触的是液氨,并且衣服已被污染,应将衣服脱下并放入双层塑料袋内。如果眼睛接触或眼睛有刺激感,应用大量清水或生理盐水冲洗20min以上。

氨气检验
方法一:用湿润的红色石蕊试纸检验,试纸变蓝证明有氨气。
方法二:用玻璃棒蘸浓盐酸或者浓硝酸靠近,产生白烟,证明有氨气。
方法三:氨气检测仪表可以定量测量空气中氨气的浓度。
上一篇:母夜叉孟州道卖人肉概括
下一篇:肺炎简笔画步骤(肺炎的画怎么画)
相关文章
为您推荐
加载中...